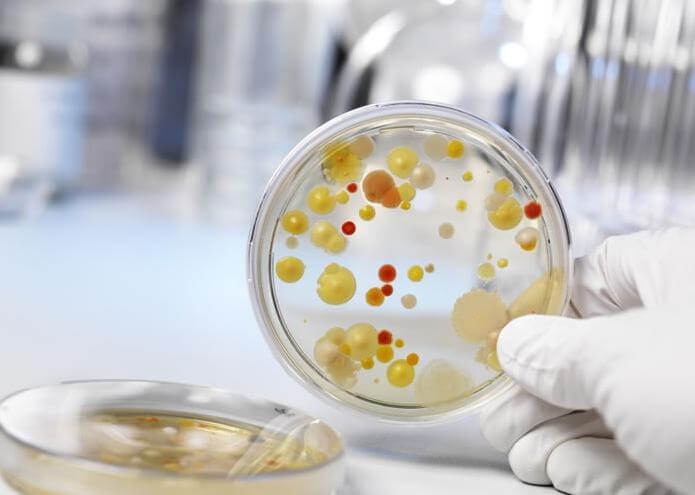
Гарднерелла вагиналис

Гарднереллез являет собой острое бактериальное заболевание мочеполовой системы, которое может возникать как у мужчин, так и у женщин. Возбудителем данной болезни является бактерия Gardnerella vaginalis.
Выделяют следующие причины развития такой половой инфекции:
- Частые смены половых партнеров (незащищенный сексуальный контакт, как у мужчин, так и у женщин).
- Несвоевременная (не достаточно частая) замена прокладок. Особенно это касается периода менструаций, когда микрофлора во влагалище особенно уязвима и подвержена попаданию различных патогенных микроорганизмов.
- Резкое нарушение в гормональном фоне (может возникнуть при половом созревании либо в период беременности).
- Ежедневное использование тонких прокладок, из-за чего создаются все условия для распространения инфекции.
- Не соблюдение правил интимной гигиены.
- Длительное лечение антибиотиками.
- Резкое понижение иммунной системы.
Помимо этого, появлению болезни Gardnerella vaginalis могут поспособствовать не вылеченный дисбактериоз, частое соблюдение несбалансированной диеты, различные факультативные патологии половой системы, а также длительное применение противозачаточных контрацептивов.
Все предрасполагающие факторы к активному прогрессированию бактерии Gardnerella vaginalis объединяет сниженный иммунитет, поскольку в таком состоянии человек становится сильно уязвим к подобного рода заболеваниям. В свою очередь дать толчок к ослаблению иммунитета может сильный стресс, хроническое переутомление, физическое истощение организма либо недавно перенесенные болезни (или хирургические вмешательства).
Существует три основных пути заражения таким видом бактериального вагинита:
- Половой пенисно-генитальный контакт — это наиболее частый путь заражения таким вагинозом. При этом стоит отметить, что бактерия может попасть от носителя инфекции к здоровому человеку, как через традиционные сексуальные контакты, так и при анальном или оральном сексе. Презерватив при этом мало чем сможет помочь. В большинстве случаев такой вид контрацепции направлен только на препятствование нежелательной беременности.
- Вертикальный путь передачи Gardnerella vaginalis случается во время родов. При этом бактерия поражает новорожденного ребенка, но, к счастью, не развивается дальше в его микрофлоре, так как у младенцев еще просто нет вещества гликогена, который так необходим данной бактерии для нормального роста.
- Контактно-бытовой путь заражения может случиться при пользовании совместными средствами гигиены (полотенцами, бельем, мочалками и т.п.). Реже попадание бактерии случается в бане или сауне, когда человек прикасается кожей гениталий к грязным сиденьям.
Исходя из вышеприведенных способов заражения, назвать Gardnerella vaginalis болезнью, передающейся исключительно половым путем, нельзя. Несмотря на это, в большинстве случаев такая патология выявляется именно у тех женщин, которые ведут активную половую жизнь и часто сменяют сексуальных партнеров. Связана такая закономерность с тем, что при незащищенном сексуальном сношении здоровая вагинальная микрофлора женщины сталкивается с пораженной мужской микрофлорой.
После этого партнер-носитель инфекции просто передает бактерию женщине, которая, попадая в благоприятные условия влагалища, начинает там активно размножаться. Что касается только носительства Gardnerella vaginalis, то инкубационный период в таком случае может длиться годами. При этом человек может и вовсе не замечать явных признаков заболевания. Несмотря на это, болезнь все равно рано или поздно начнет себя проявлять.
Более того, гарднелла будет постоянно угнетать иммунитет, делая человека ослабленным и восприимчивым к другим патологиям. Чтобы выявить данный неспецифический вагинальный анаэроб, следует взять ДНК анализ, посев (мазок) из половых органов и анализ ПЦР. Также важно сделать это как можно раньше, ведь своевременная диагностика и начатое лечение может уберечь от развития опасных последствий.
Гарднерелла вагиналис: симптомы и диагностика
В большинстве случаев гарднерелла вагиналис у мужчин практически никак не проявляется, так как зачастую они являются только носителями данной инфекции и сами ею не болеют (нет выраженной симптоматики). Редко могут наблюдаться незначительные воспалительные процессы в уретре, небольшие гнойные выделения и боль при мочеиспускании.
В более запущенных случаях у мужчины (при длительном поражении гарднереллой вагиналис) может развиваться бесплодие, воспаление яичек и простатит. Следует отметить, что более чем в 95% всех случаев при поражении гарднереллой вагиналис мужчина даже не будет догадываться о том, что он болен и заражает свою партнершу при сексуальных контактах.
У женщин гарднерелла вагиналис сопровождается явными воспалительными процессами во влагалище и шейке матки. Главным признаком данного заболевания будет появление слизистых или гнойных выделений из влагалища, которые будут иметь выраженный неспецифический запах «испорченной рыбы».
Особенно явно это заметно при половом контакте без применения презерватива. Также часто у больной наблюдается зуд и жжение в половых органах, появление липких желтоватых выделений и боль при половом акте. Реже бывает дискомфорт во время мочеиспускания, раздражение и покраснение слизистой вагины.
Важно знать
Небольшое содержание бактерии гарднереллы вагиналис считается нормой и не вызывает никаких особых симптомов у женщины. Более того, как показывает статистика, более 30 % всех сексуально активных женщин являются носителями данной инфекции и нисколько от нее не страдают.
Ситуация меняется в том случае, когда бактерии гарднереллы вагиналис становится слишком много и она начинает вредить микрофлоре женщины. Особенно это опасно при пониженном иммунитете и беременности. Для выявления инфекции гарднереллы вагиналис пациенту следует взять мазок из влагалища (уретры для мужчин) и отправить его для дальнейшего микроскопического исследования.
Это самый верный способ, который позволит точно выявить возбудителя (очаг) болезни, его тип и т.п. В качестве вспомогательных диагностических методик рекомендуется провести осмотр у гинеколога (уролога), взять анализ на другие анаэробные бактерии и проверить чувствительность к бактерии методом ПЦР.
Gardnerella vaginalis – это бактерия, которая обычно обитает во влагалище и может быть частью нормальной микрофлоры. Однако, при нарушении баланса микробов, она может стать причиной вагиноза. Врачи отмечают, что основными факторами, способствующими развитию этого состояния, являются изменения уровня гормонов, частые смены половых партнеров, а также использование агрессивных средств гигиены. Передача Gardnerella vaginalis происходит преимущественно половым путем, однако она не считается венерическим заболеванием. Важно помнить, что наличие данной бактерии не всегда приводит к симптомам, но при их появлении, таких как зуд и выделения, необходимо обратиться к врачу для диагностики и лечения. Врачебные рекомендации включают соблюдение правил личной гигиены и, при необходимости, применение антибиотиков.

Гарднереллез у женщин: особенности проявления, опасности и лечение при беременности
Общая схема проявлений гарднереллеза у женщин имеет три этапа: носительство, активная фаза (период проявления заболевания), нарушение микрофлоры или развитие бактериального вагиноза.
После первичного заражения данный венерический возбудитель (гарднереллез у женщин) «приживается» во влагалище и при благоприятных условиях начинает активное размножение.
Если же у женщины сильный иммунитет, то, скорее всего, большая часть бактерий погибнет, так и не «пустив корни». При этом гарднереллез у женщины будет иметь форму носительства. После первой фазы наступает период активного размножения бактерии. При этом у больной будет зуд, жжение и неприятный запах из половых органов. Также не редко бывают слизистые выделения и воспаление. Уже при первом появлении данных симптомов рекомендуется обращаться к врачу гинекологу, и не дожидаться пока гарднереллез у женщин станет проявлять себя «во всей красе».
Как показывает врачебная практика, гарднереллез у женщин имеет длительное протекание, часто сопровождающееся осложнениями. Опасность данного заболевания состоит в том, что репликация бактерий изменяет общий баланс микрофлоры женщины. В свою очередь, это провоцирует развитие вагинального дисбактериоза или дисбиоза.
При этом данная лактобацилла способствует тому, что женщина становится очень сильно подверженной различным воспалительным болезням мочеполовой системы. Именно по этой причине очень важно своевременно диагностировать и лечить гарднереллез у женщин. При выявлении гарднереллеза у женщин в период беременности назначать традиционные антибиотики запрещено, так как они могут отрицательно воздействовать на плод.
В таком случае рекомендуется использование специальных вагинальных свеч, которые обладают сильным противомикробным и антибактериальным эффектом. Длительность подобного лечения должна подбираться врачом индивидуально. Также в таком случае лечебную терапию должен проходить и половой партнер пациентки.
Как лечить гарднереллу: разные способны терапии гарднерелла вагиналис
Перед выяснением, как нужно лечить гарднереллу, стоит сказать о важности терапии именно у мужского пола. Дело в том, что даже при отсутствии явных симптомов болезни у человека будет развиваться хроническое воспаление и нарушение иммунитета. Это в свою очередь, способно привести к серьезным нарушениям половой функции мужчины (уретрит при распространении уреаплазмы, простатит, нарушение мочеиспускания и даже бесплодие).
Более того, если мужчина является активным носителем, то при каждом незащищенном половом контакте он будет заражать женщину, провоцируя у нее нарушение микрофлоры, понижение количество полезных лактобактерий и развитие дисбактериоза. Что касается гарднеллеза у женщин, то он должен обязательно лечиться, ведь от этого во многом зависит общее функционирование половой системы пациентки и даже состояние ее репродуктивной функции.
Gardnerella vaginalis — это бактерия, которая обычно обитает во влагалище и играет роль в поддержании нормальной микрофлоры. Однако при нарушении баланса она может стать причиной бактериального вагиноза, что вызывает дискомфорт и неприятные симптомы. Люди часто обсуждают, что основными причинами размножения Gardnerella являются стрессы, изменение гормонального фона, а также частая смена половых партнеров. Передача бактерии происходит не только половым путем, но и через использование общих предметов гигиены. Важно помнить, что наличие Gardnerella не всегда означает наличие заболевания, но при появлении симптомов стоит обратиться к врачу для диагностики и лечения. Правильная гигиена и поддержание здорового образа жизни могут помочь предотвратить проблемы, связанные с этой бактерией.

Как лечить гарднереллу препаратами
Если у вас диагностировали гарднерелла вагиналис, как лечить ее посоветует квалифицированный специалист, зачастую требуется длительная терапия и тщательно подобранные медикаментозные препараты. Традиционное лечение предусматривает назначение иммуномодулирующих препаратов и антибиотиков. Принимать их нужно не менее десяти дней подряд. После этого повторно сдаются анализы и при необходимости терапия продляется.
Многие задаются вопросом, как лечить гарднереллу так, чтобы не заразить полового партнера. Ответ при этом прост: на период терапии нужно отказаться от интимной связи, особенно без использования презерватива. Гинеколог (уролог) должен лично контролировать процесс проведения общей терапии для лечения гарднерелла вагиналис. Как лечить данную инфекцию знает только специалист, ни в коем случае не принимайте лекарства без его назначения и не занимайтесь самолечением.
Очень эффективными в терапии считаются антибиотики. Они направлены на подавление активности бактерий. Обычно для этой цели назначаются Метронидозол или Клиндамицин. Использовать их можно в виде таблеток, вагинальных свеч или гелей. Длительность лечения антибактериальными препаратами должна составлять десять дней.
На втором этапе лечения пациенту нужно «заселить» в микрофлору «хорошие» бактерии (лактобактерии). Наиболее действенными средствами данной группы являются препараты Ацилакт, Лактонорм и Лактобактерин. В период лечения пациенту нужно соблюдать особое питание. Диета предусматривает полный отказ от спиртного, жареного, жирного, сладкого, мучного и острого.
Основу рациона должны составлять каши, кисломолочные продукты, супы, рыба и овощи. Для профилактики образования дисбактериоза в кишечнике назначаются бифидобактерии (пробиотики). Лучшими считаются Линекс или Филак Форте. Спустя месяц после начала лечения больному нужно сдать повторно все анализы. Дальнейшая терапия зависит от полученных результатов.
Гарднерелла вагинализ: как лечить с помощью народной медицины
Народная терапия может практиковаться, однако при не сильно запущенном состоянии данного заболевания и под строгим наблюдением врача. Одним из лучших рецептов для такого лечения являются применение сидячих ванночек с добавлением отвара березовых почек, ромашки или коры дуба.
Данные растительные жидкости обладают выраженным антибактериальным эффектом, поэтому помогут быстрее устранить очаг инфекции. В качестве вспомогательной терапии женщинам разрешается установление бинтовых тампонов, промоченных в свежем кефире. Он будет нормализовать микрофлору влагалища.

Инфекция гарднерелла у мужчин: симптомы, осложнения и профилактика
Инфекция гарднелла у мужчин имеет следующие этапы развития:
- Период носительства, когда заболевание никак себя не проявляет.
- Появление активной репликации бактерии и распространения инфекции гарднереллы.
- Появление первых признаков заболевания у мужчины (зуд, жжение, покраснение, появление небольших язв на головке члена). После этого появиться боль при мочеиспускании и жжение во время полового акта.
- Развитие болезней на фоне инфекции гарднереллы. При этом у мужчины может возникнуть баланопостит или уретрит.
Если не начать своевременное лечение, то инфекция гарднерелла начнет распространяться по организму вместе с кровью, поражая не только слизистые оболочки, но и также органы. Таким образом, у больного может развиться абсцесс легких, воспаление мочевого пузыря, сепсис и синдром Рейтера.
Стоит знать, что инфекция гарднерелла, если она будет выявлена при беременности, способна вызвать цистит, преждевременные роды, инфицирование плода либо его рождение с аномалиями. Более того, у женщины инфекция гарднерелла способна вызвать заражение крови, хроническое воспаление, ухудшение работы мочевого пузыря и нарушение детородной функции.
Чтобы снизить риск заражения инфекцией гарднереллы, следует соблюдать такие врачебные рекомендации:
- Два раза в год проходить контрольное обследование у гинеколога (у уролога мужчинам) и сдавать анализы у венеролога.
- Иметь постоянного сексуального партнера и избегать случайных половых связей. С непостоянными половыми партнерами нужно всегда пользоваться презервативом.
- Своевременно лечить все болезни половой системы, которые повышают риск развития инфекции гарднерелла.
- Носить нижнее белье только из натуральных тканей.
- Тщательно соблюдать интимную гигиену.
- Укреплять свой иммунитет (заниматься спортом, избегать стрессов, полноценно питаться).
- Ни в коем случае не пользоваться чужими средствами личной гигиены и не позволять брать свои полотенца и т.п. даже близким людям.
Вопрос-ответ
Откуда берется гарднерелла у женщин?
Причины заболевания гарднереллезом могут быть такие как: снижение иммунитета, стресс, изменения гормонального фона (из-за беременности, родов, аборта и т. Д. ), смена климата, синтетическое белье и одежда, длительный прием антибиотиков, неправильное питание, хронические заболевания кишечника, иммунодефицит.
Как можно заразиться Гарднереллой?
Причины гарднереллеза Передача бактерии, как правило осуществляется половым путем при незащищенном контакте. Теоретически возможен также контактно-бытовой путь передачи и заражение во время родов.
Можно ли заразиться гарднереллой без полового контакта?
Таким образом, гарднереллез у женщин может развиваться без вмешательства извне. В то же время мужчины в своей мочеполовой системе не имеют таких бактерий, следовательно, возбудители могут попасть в мужской организм только при половом контакте.
Передается ли гарднерелла от мужчины к женщине?
Мужчина не может заразиться бактериальным вагинозом, но может стать носителем инфекции и спровоцировать развитие или рецидив заболевания у партнерши. Передается ли бактериальный вагиноз половым путем? БВ не относится к ЗППП. Это нарушение микрофлоры влагалища из-за усиленного роста болезнетворных бактерий.
Советы
СОВЕТ №1
Регулярно проходите гинекологические осмотры. Это поможет выявить возможные инфекции, включая Gardnerella vaginalis, на ранних стадиях и предотвратить их развитие.
СОВЕТ №2
Обратите внимание на личную гигиену. Используйте мягкие, неароматизированные средства для интимной гигиены и избегайте использования дезодорантов и других агрессивных продуктов в области гениталий.
СОВЕТ №3
Избегайте незащищенных половых контактов. Использование презервативов может снизить риск передачи Gardnerella vaginalis и других инфекций, передающихся половым путем.
СОВЕТ №4
Следите за своим питанием и уровнем стресса. Здоровый образ жизни и сбалансированное питание могут укрепить иммунную систему и помочь организму бороться с инфекциями.